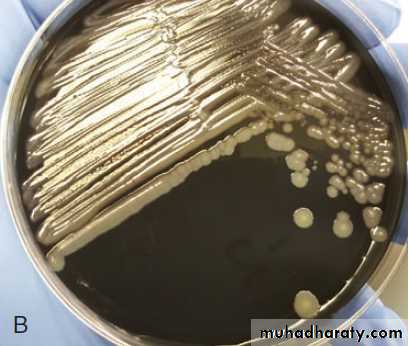

Gram Negative Bacilli Legionella pneumophila
Intracellular Pathogens
Some bacteria (eg, M. tuberculosis, L. monocytogenes, Brucella spp. and Legionella spp.)Live and grow in the hostile environment within polymorphonuclear cells, macrophages or monocytes.
The bacteria accomplish this feat by several mechanisms:
they may avoid entry into phagolysosomes and live within the cytosol of the phagocyte,
they may prevent phagosome–lysosome fusion and live within the phagosome,
they may be resistant to lysosomal enzymes and survive within the phagolysosome.
Legionella pneumophila
In 1976 during an American Legion convention in Philadelphia, 221 persons become ill with pneumonia, and 34 of them died of mysterious disease.more illness from Legionnaires' disease is being detected now.
Legio= Army
Ella= Small
Pneumo=Lung
Philia= Love
The 4 sisters “Ella”
worship in the
“Cysteine” chapel:
• Francisella
• Brucella
• Legionella
• Pasteurella
Legionella pneumophila
Legionella are fastidious, aerobic gram negative flagellated, non-spore forming bacteria,That are 0.5-1 µm wide & 2-50 µm length,
They are often stain poorly by Gram’s method & not easy stain of clinical specimens (only growth on agar media), Staining with Silver impregnation methods.
It is called water organism,
The air conditioner is the easy to cause legionella infection,
Facultative intracellular.
Legionella pneumophila
Fastidious microorganisms requiring increased iron, α-ketoglutarate cysteine for laboratory culture (BCYE, Buffered Charcoal, Yeast Extract).Legionella are associated with two respiratory syndromes: Pontiac fever and Legionnaires’ disease.
Most cases are associated with serogroup 1 followed by 4, and 6.
Legionella pneumophila
Reservoir:
Legionella inhabits on aquatic bodies:
• Natural water sources, such as rivers or even inside amebae,
• Artificial aquatic sources, such as air conditioners.
• The bacteria are capable of surviving extreme range of environmental conditions for long periods. (14 months in water).
Legionella pneumophila
Transmission:• Aspiration (MC mode) via oropharyngeal colonization or directly via drinking of contaminated water,
• Aerosols from contaminated air conditioners, nebulizers, and humidifiers,
• Direct instillation into the lungs during respiratory tract manipulations,
• There is no man to man transmission, there is no animal reservoir and no carrier.
Legionella pneumophila
Pathogenesis:Facultative intracellular pathogen,
The organism gains entry to the upper respiratory tract by aspiration of water containing the organism or by inhalation of a contaminated aerosol,
Attachment and invasion to respiratory mucosa by Mip protein, a virulence factor important for macrophage invasion. Which promotes adherence.
Inside the cell the individual bacteria are contained within phagosomal vacuoles, but the defense mechanisms of the macrophages stop at the point & fails to fuse with lysosomal granules.
Legionella pneumophila
Pathogenesis:
Coiling phagocytosis: Macrophages phagocytose legionella by a coiling mechanism, A phagocyte pseudopodia coils around the bacterium as the organism is internalized.
The bacteria surround themselves in a membrane-bound vacuole that does not fuse with lysosomes that would otherwise degrade the bacteria. In this protected compartment, the bacteria multiply.
Legionella pneumophila
Infection Cycle of Legionella
Type IV secretion SystemLegionella pneumophila
Risk factors (Predisposing factors).Smoking,
Alcohol,
Age > 55,
Hospitalization,
Chronic lung disease (chronic bronchitis and emphysema) or cardiovascular disease,
Diabetes mellitus,
Immunodeficiency status (steroid and other immunosuppressive treatment (as in renal transplantation), cancer chemotherapy, and, more recently, as a complication of anti–tumor necrosis factor (TNF)-α therapy) HIV.
Legionella pneumophila
Clinical Finding:There are three distinctly different presentations: Legionnaires Disease (LD) and Pontiac fever and Extrapulmonary Legionellosis.
The clinical picture can vary from a mild influenza-like illness to a severe pneumonia.
• 1- Legionnaires disease:
This is an atypical, acute lobar pneumonia with multisystem symptoms (Atypical pneumonia).
Symptoms develop after an incubation period ranging from 2 to 10 days.
Early symptoms may be relatively nonspecific: fever, malaise, myalgia, anorexia, and/or headache.
Legionellosis is an atypical pneumonia and must be distinguished from other similar pneumonias such as Mycoplasma pneumonia, viral pneumonia, psittacosis, and Q fever.
The clinical picture can vary from a mild influenza-like illness to a severe pneumonia accompanied by
Legionella pneumophila
Clinical Finding:• 1- Legionnaires disease:
It is responsible for 10–50% of cases of nosocomial pneumonia. Serogroup 6 is more commonly involved in hospital outbreaks.
Non-bloody diarrhea, proteinuria, and microscopic hematuria. Although cough is a prominent symptom, sputum is frequently scanty and non-purulent. Hyponatremia (serum sodium ≤130 mEq/L) is an important laboratory finding that occurs more often in Legionella pneumonia than in pneumonia caused by other bacteria
Legionella pneumophila
Clinical Finding:
• 1- Legionnaires disease:
Chest radiography reveals patchy,
often multi-lobar consolidation.
Legionella pneumophila
Clinical Finding:• 2- Pontiac Fever:
The Pontiac fever is a mild, flu like form of Legionella infection that does not result in pneumonia.
headache, fever, malaise and myalgia that last 2 to 5 days and then subside without medical intervention.
This illness is self-limited and does not require treatment with antibiotics.
Legionella pneumophila
Clinical Finding:• 3- Extrapulmonary Legionellosis:
The most common extrapulmonary site is heart; (myocarditis, pericarditis and prosthetic-valve endocarditis).
Other manifestations include: Sinusitis, peritonitis, pyelonephritis, skin and soft tissue infection.
Legionella pneumophila
Laboratory Diagnosis:
Several methods, such as direct examination, culture, and antigen and antibody detection, are available for the laboratory diagnosis of infections caused by Legionella spp. Legionnaires’ disease is best diagnosed using a combination of culture and urine antigen detection. Diagnosis of Pontiac fever is usually limited to serology. Most laboratories use more than one method to maximize their diagnostic capabilities.
Legionella pneumophila
Laboratory Diagnosis:Specimens:
• Sputum, bronchoalveolar lavage, and bronchial washings, pleural fluid, lung biopsy specimens,
• Gram stains reveal many neutrophils but no bacteria, the bacteria stains poorly with Gram stain, visualize with silver stain (Silver stains are sometimes used on tissue specimens),
• specimens can be diagnostic, but the test has low sensitivity compared with culture.
Legionella pneumophila
Laboratory Diagnosis:• Specimens are cultured on BCYE agar (Buffered Charcoal, Yeast Extract),
• Legionella grow in air or 3% to 5% carbon dioxide at 35°C after 3 to 5 days.
• Cultured organisms can be rapidly identified by direct immunofluorescence Antibody (DFA) staining, (fluorescein-labeled monoclonal or polyclonal antibodies directed against Legionella species are used, sensitivity about 75 %),
• Levels of antibodies to legionellae rise slowly during the illness.
• Serologic tests have a sensitivity of 60–80% and a specificity of 95–99%.
• Serologic tests are most useful in obtaining a retrospective diagnosis in outbreaks of Legionella infections.
Legionella pneumophila
Laboratory Diagnosis:• Urinary Antigen Tests Enzyme-linked immunoassays (ELISA): detect soluble Legionella-specific lipopolysaccharide antigens excreted in the urine of infected patients.
• Molecular assays, such as polymerase chain reaction (PCR), that amplify genes such as mip and 16SrRNA,
• Chest X Ray
•
Legionella pneumophila
Urine Antigen TestBlood Specimen Testing the Serum
Legionella pneumophila
Fluorescent antibody–stained
Colonies of on buffered charcoal–yeast extract agar demonstrating blue-greenLaboratory Diagnosis:
(BCYE)
Legionella pneumophilaTreatment:
• macrolides (e.g. Azithromycin, Clarithromycin) or Fluoroquinolones (e.g. Ciprofloxacin, Levofloxacin), with rifampin (immunocompromised patients).
• Penicillin, cephalosporins of all generations, and aminoglycosides are not effective and should not be used (The organism frequently produces β-lactamase, and so penicillin and cephalosporins are less effective).
Prevention: Routine Decontamination Of Air-Conditioner Cooling